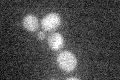
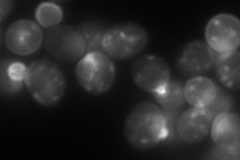
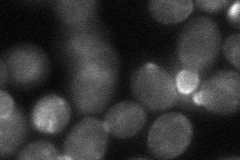
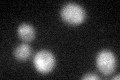
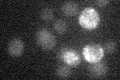

View description
Catalytic subunit of 1,3-beta-D-glucan synthase, functionally redundant with alternate catalytic subunit Gsc2p; binds to regulatory subunit Rho1p; involved in cell wall synthesis and maintenance; localizes to sites of cell wall remodeling
Localization:
Intensity:
Fold change:
Significance:
-
C’ GFP library in SD
below threshold15.4 -
N' NOP1pr-GFP in SD
cell periphery,punctate,bud155.114 -
N' TEF2pr-mCherry in SD

cell periphery,vacuole,bud151.291 -
N' NATIVEpr-GFP in SD

cell periphery,bud neck119.46 -
N' TEF2pr-VC and Cyto-VN in SD
bud40.3617 -
C’ GFP library in SD+DTT
cytosol15.931.03No -
C’ GFP library in SD+H2O2

cytosol15.340.99No -
C’ GFP library in Starvation Media
cytosol16.131.04No -
C’ GFP library on the background of Pup2-DaMP

below threshold -
C’ GFP library on the background of CCT mutant

below threshold15.41291.00071No
